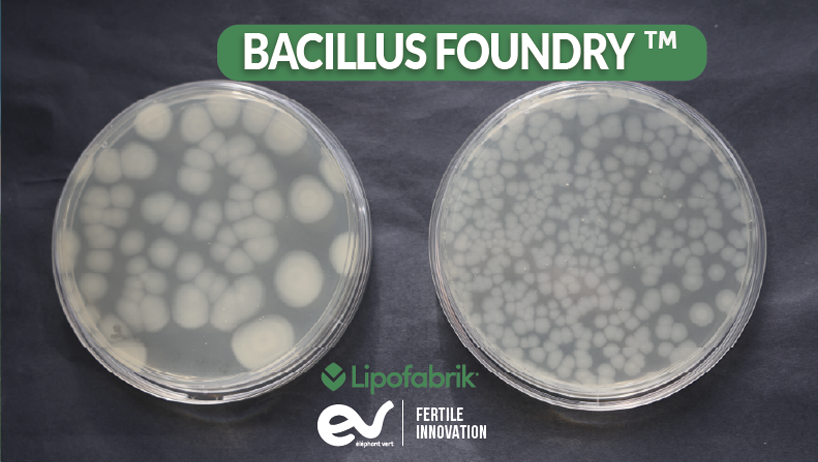

BACILLUS FOUNDRY™, a plataforma inovadora de microrganismos da Lipofabrik que molda o futuro da agricultura sustentável.
Com o estabelecimento oficial do Bacillus Foundry™, A Lipofabrik — o centro de P&D do Elephant Vert Group — está transformando ciência de ponta em biossoluções de última geração, prontas para os mercados globais. À medida que as mudanças climáticas remodelam a agricultura e as pressões ambientais se intensificam, essa nova plataforma posiciona a empresa na vanguarda da inovação, oferecendo soluções mais resilientes, sustentáveis e de alto impacto para agricultores em todo o mundo.

Através da perspectiva de Yazen Yaseen, chefe do departamento de P&D do Grupo EV (LIPOFABRIK), descubra como a EV está trilhando um caminho diferenciado e orientado por especialistas em biossoluções.
Dentro do Bacilo Fundição™A plataforma de três pilares que impulsiona biossoluções mais rápidas e seguras.
A Lipofabrik desenvolveu um motor de inovação único: o Bacilo Fundição™. Esta plataforma foi criada para dominar o desenvolvimento microbiano e acelerar a entrega de soluções sustentáveis e de alto desempenho. Ela está estruturada em torno de três pilares estratégicos:
- Avaliação e seleção de cepas
- Desenvolvimento e otimização de bioprocessos, ou seja, intensificação de processos e produção de metabólitos de alto rendimento, possibilitando extração eficiente e escalável em nível industrial.
- Mitigação de riscos relacionados à variabilidade ambiental, bem como avaliações de risco ambiental exigidas para aprovação regulatória.
Essa estrutura integrada permite um desenvolvimento de produtos mais rápido, seguro e confiável, desde o laboratório até o campo.
Solucionando desafios agronômicos reais: O Bacilo Fundição™ é a pedra angular da Plataforma de Tecnologia de P&D da Eléphant Vert, fornecendo soluções de alto desempenho.
A Plataforma Tecnológica garante que as novas soluções atendam diretamente às necessidades reais dos agricultores. Bacilo Fundição™ É o motor que fornece a substância ativa para biossoluções, projetado para oferecer alta eficácia consistente – comparável ou superior às referências químicas – mantendo-se, ao mesmo tempo, com preço competitivo e fácil de usar, sem restrições operacionais.
O desenvolvimento do produto segue um rigoroso processo de avaliação, começando com a triagem in vitro contra patógenos-alvo, seguida pela confirmação in planta e ensaios de campo em múltiplos locais, conduzidos em parceria com os produtores. O feedback dos agricultores é integrado em todo o processo de desenvolvimento para melhorar continuamente a eficiência, a confiabilidade e a facilidade de aplicação.
Em paralelo, a plataforma investiga os mecanismos de ação de todas as soluções, sejam elas direcionadas a patógenos fúngicos, bacterianos ou de insetos, ou que influenciem a fisiologia das plantas. Essa compreensão mecanística apoia a inovação contínua e o aprimoramento dos produtos.
Escolhendo Bacillus subtilis: O caminho científico, seguro e de alto desempenho para biossoluções de próxima geração.
Bacilo subtilis É um dos microrganismos mais estudados e amplamente reconhecido como uma fábrica de metabólitos secundários (Trabelsi et al., 2021). Possui o status GRAS (Geralmente Reconhecido como Seguro) da FDA dos EUA, o que significa que não representa risco para humanos. Encontrado naturalmente no solo, interage com plantas e microrganismos benéficos, tornando-o particularmente relevante para aplicações agrícolas.
Com mais de 5.000 genes, incluindo 5.033 sequências codificadoras de proteínas, B. subtilis Produz inúmeras enzimas de relevância industrial, como proteases, amilases e celulases (Sohail et al., 2025; Harwood et al., 2018). Aproximadamente 5% de seu genoma é dedicado à biossíntese de metabólitos secundários (Iqbal et al., 2023), gerando peptídeos não ribossômicos, peptídeos ribossômicos, policetídeos, bacteriocinas e moléculas voláteis.
Esses metabólitos exibem fortes propriedades de biocontrole e bioestimulantes, posicionando-se como... B. subtilis como pedra angular para as biossoluções de próxima geração na agricultura, segurança alimentar e biotecnologia (Iqbal et al., 2023; Yaseen et al., 2017) como BaciloOs produtos à base de [material] são cada vez mais reconhecidos como alternativas sustentáveis aos insumos químicos.
Os fundadores e a equipe da Lipofabrik são especialistas acadêmicos de longa data em B. subtilis e seus metabólitos, construídos com base em décadas de pesquisa para criar a Bacillus Foundry.™ e transformar esse conhecimento científico em soluções práticas e escaláveis.

Um caminho mais inteligente para as Biosoluções: extraindo B. subtilis metabólitos para resultados de campo consistentes e de alto desempenho
Um grande desafio persiste em todo o setor: garantir a estabilidade e o desempenho de microrganismos vivos em condições ambientais reais.
O Bacilo Fundição™ aborda essa limitação desenvolvendo uma nova geração de soluções de biocontrole e bioestimulantes centradas na extração de metabólitos ativos chave produzidos por B. subtilis que pode ser uma molécula pura ou uma mistura de moléculas produzidas pela mesma cepa. Essa abordagem garante que a atividade biológica seja mantida mesmo sob condições de campo exigentes, enquanto os processos de produção natural são otimizados para alcançar competitividade de custos industriais. Hoje, a plataforma se tornou rapidamente um pilar estratégico de nosso portfólio de desenvolvimento e P&D, servindo como uma fonte fundamental de candidatos a produtos inovadores tanto em biocontrole quanto em bioestimulação. Sua primeira inovação lançada no mercado, o NOVASTIM, é um exemplo disso.®, é um bioestimulante foliar único à base de B. subtilis metabólitos do sobrenadante. Já disponível em diversos países, demonstrou excelente desempenho em múltiplas dimensões, incluindo qualidade da colheita, floração e frutificação, tolerância ao estresse e conservação pós-colheita.
Para fortalecer a competitividade a longo prazo, a estratégia de inovação inclui a proteção sistemática por patentes de futuros produtos de biocontrole, garantindo bases sólidas de propriedade intelectual para as soluções futuras.
Referências
Trabelsi, H., Dhali, D., Yaseen, Y., Leclère, V., Jacques, P., & Coutte, F. (2021). Fábricas de células microbianas baseadas em Bacillus subtilis. Arquivo de Ciência Aberta HAL.
Sohail, H., Naveed, M., Aziz, T., Mohamed, RAEH, & AlJoufi, FA (2025).
Análise do genoma completo de Bacillus subtilis MBBL2: caracterização genômica e genômica comparativa. Genômica Funcional e Integrativa, 25, Artigo 167. [link.springer.com]
Harwood, CR, Mouillon, JM., Pohl, S., & Arnau, J. (2018).
Produção de metabólitos secundários e segurança de membros industrialmente importantes do grupo Bacillus subtilis. FEMS Microbiology Reviews, 42(6), 721–738. [academic.oup.com]
Iqbal, S., Begum, F., Rabaan, AA, e outros. (2023).
Classificação e potencial multifacetado dos metabólitos secundários produzidos por Bacilo subtilis Grupo: Uma revisão abrangente. Moléculas, 28(3), 927.
[mdpi.com]
Yaseen, Y., Gancel, F., Béchet, M., Drider, D., & Jacques, P. (2017). Estudo da correlação entre a expressão do promotor da fengicina e sua produção por Bacillus subtilis em diferentes condições de cultivo e o impacto na produção de surfactina.. Arquivos de Microbiologia, 199, 1371–1382. [link.springer.com]